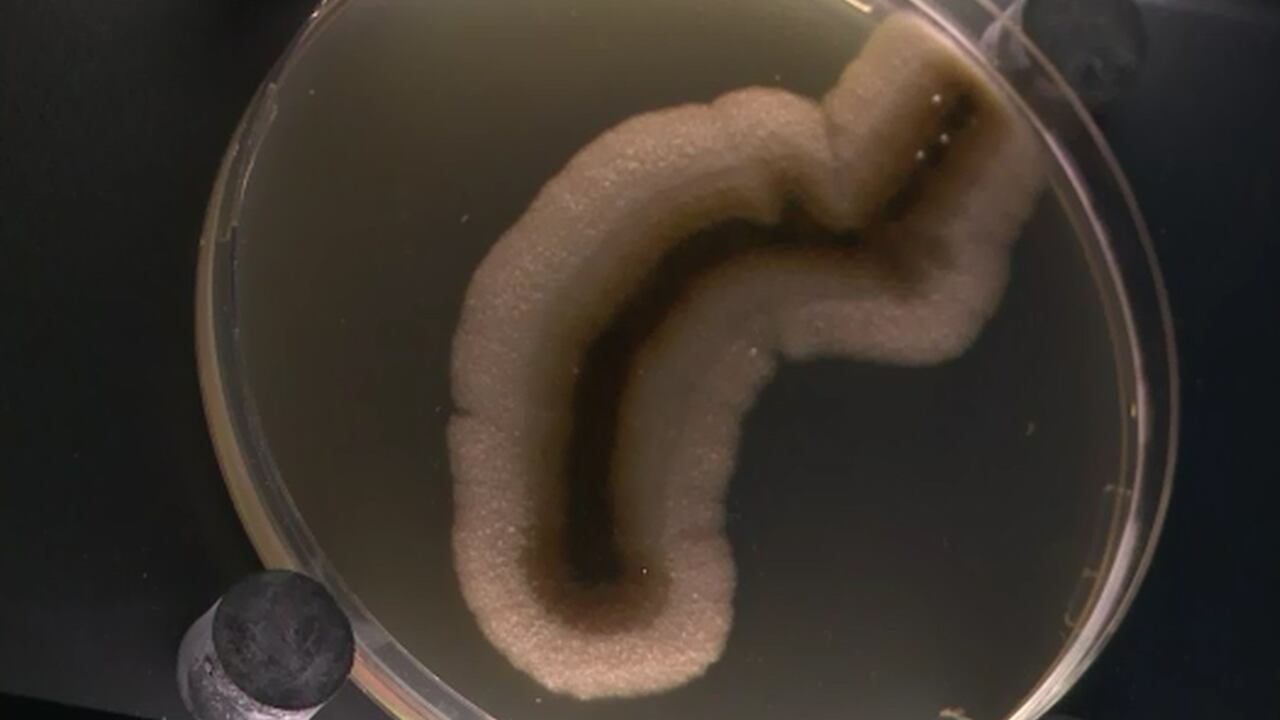

Con alimento adecuado en las condiciones de laboratorio adecuadas, microbios recolectados de sedimentos del fondo marino de hasta 100 millones de años pueden revivir y multiplicarse.
Un equipo de investigación la Agencia de Ciencia y Tecnología de la Tierra y el Mar de Japón (JAMSTEC) y la Escuela de Oceanografía de Graduados de la Universidad de Rhode Island reunió muestras de sedimentos antiguos hace diez años durante una expedición al Gyre del Pacífico Sur, la parte del océano con la productividad más baja y la menor cantidad de nutrientes disponibles para alimentar la red alimentaria marina. El resultado se publica en Nature Communications.
Desarrollan tapabocas inteligente anticoronavirus que se conecta al celular
"Nuestra pregunta principal era si la vida podría existir en un ambiente con tal limitación de nutrientes o si se trataba de una zona sin vida", dijo el autor principal del artículo, Yuki Morono, científico principal de JAMSTEC. "Y queríamos saber por cuánto tiempo los microbios podrían mantener su vida en una ausencia de alimentos".
En el fondo marino, hay capas de sedimentos que consisten en nieve marina (desechos orgánicos continuamente provenientes de la superficie del mar), polvo y partículas transportadas por el viento y las corrientes oceánicas. Pequeñas formas de vida como los microbios quedan atrapados en este sedimento.
A bordo del buque de investigación JOIDES Resolution, el equipo perforó numerosos núcleos de sedimentos a 100 metros debajo del fondo marino y casi 6.000 metros debajo de la superficie del océano. Los científicos descubrieron que el oxígeno estaba presente en todos los núcleos, lo que sugiere que si el sedimento se acumula lentamente en el fondo marino a una velocidad de no más de un metro o dos cada millón de años, el oxígeno penetrará desde el fondo marino hasta el sótano. Tales condiciones hacen posible que los microorganismos aeróbicos, aquellos que requieren oxígeno para vivir, sobrevivan por escalas de tiempo geológicas de millones de años.
boratorio afinados, los científicos, liderados por Morono, incubaron las muestras para convencer a sus microbios para que crecieran. Los resultados demostraron que, en lugar de ser restos de vida fosilizados, los microbios en el sedimento habían sobrevivido y eran capaces de crecer y dividirse.
"Sabíamos que había vida en sedimentos profundos cerca de los continentes donde hay mucha materia orgánica enterrada", dijo el profesor de la Escuela de Oceanografía de la Universidad de Rhode Island y coautor del estudio Steven D‘Hondt. "Pero lo que encontramos fue que la vida se extiende en las profundidades del océano desde el fondo marino hasta el sótano rocoso subyacente".
Morono se sorprendió inicialmente por los resultados. "Al principio era escéptico, pero descubrimos que hasta el 99,1% de los microbios en sedimentos depositados hace 101.5 millones de años todavía estaban vivos y listos para comer", dijo.
Con la capacidad recientemente desarrollada para crecer, manipular y caracterizar microorganismos antiguos, el equipo de investigación espera aplicar un enfoque similar a otras preguntas sobre el pasado geológico. Según Morono, la vida de los microbios en el subsuelo es muy lenta en comparación con la vida que está por encima, por lo que la velocidad evolutiva de estos microbios será más lenta. "Queremos entender cómo o si estos antiguos microbios evolucionaron", dijo. "Este estudio muestra que el subsuelo es una excelente ubicación para explorar los límites de la vida en la Tierra".
Antes de mirar hacia adelante para futuras investigaciones, D‘Hondt se tomó el tiempo para reflexionar sobre el logro de Morono. "Lo más emocionante de este estudio es que muestra que no hay límites para la vida en el viejo sedimento del océano mundial", dijo D‘Hondt. "En el sedimento más antiguo que hemos perforado, con la menor cantidad de alimentos, todavía hay organismos vivos, y pueden despertarse, crecer y multiplicarse".
*Con información de Europa Press.